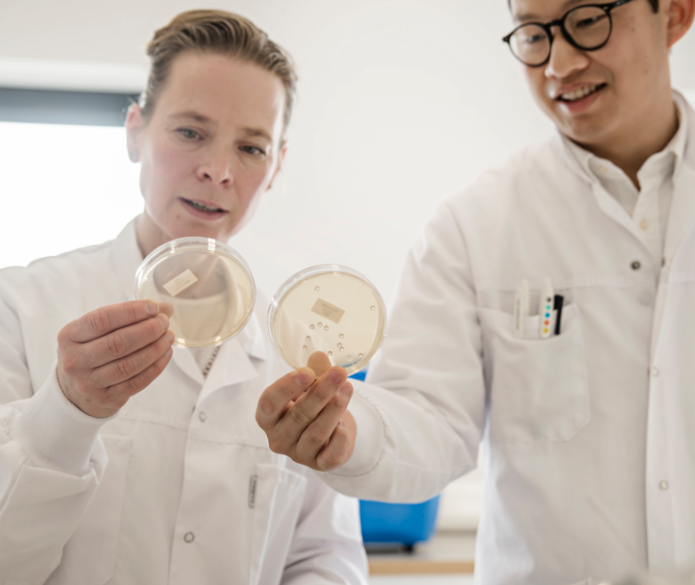

プロデンティス アップル味 30錠
希望小売価格 ¥4,309(税込)
¥4,309
プロデンティスが選ばれる理由
30年以上にわたるプロバイオティクス研究の軌跡

オーラルヘルス(お口の健康)とは?

口腔内プロバイオティクスの仕組みとは?
その他の商品

|

| |
|---|---|---|
| チャイルドヘルス 10ml (50回分) (無味無臭) | プロデンティス リキッド ミント味 10ml(50回分) | |
| 形式 | リキッド 10ml | リキッド 10ml |
| 推奨年齢 | 生後0日から使用可能 | 3歳以上対象(ミント味のため) |
| 効果・メリット:健康な方の健康維持をサポートします | 腸内および消化器の健康 | 口腔の健康をサポート |
| 用量 | 1日5滴〜 | 1日5滴〜 |
|
¥7,182 |
¥7,182 |








